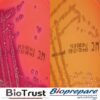

Επιλέγοντας τον παρακάτω σύνδεσμο θα δείτε αναλυτικά όλες τις χρήσιμες πληροφορίες για το συγκεκριμένο προϊόν (συσκευασία,φύλαξη, χρόνος ζωής)
MAC CONKEY 100ml BIOPREPARE
Ένα θρεπτικό υλικό για την απομόνωση των εντεροβακτηριδίων
Τα gram(-) αρνητικά εντεροβακτηρίδια που ζυμώνουν την λακτόζη, παράγουν κόκκινες η ροζ αποικίες. Τα χολικά άλατα Νο 3 και το κρυσταλικό ιώδες αναστέλλουν την ανάπτυξη των gram(+) θετικών κόκκων. Ο δείκτης ουδέτερο ερυθρό αλλάζει χρώμα με τη διάσπαση της λακτόζης.
Συσκευασία:1 τμχ (φιαλίδιο 100ml)